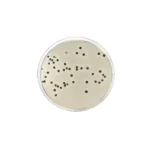
محیط کشت برد پارکر

مقایسه کالاها
- برای افزودن کالا به لیست مقایسه کلیک کنید
جستجو
 متانول مایان گستر
متانول مایان گستر محیط کشت BHI آگار آتیه سلامت
محیط کشت BHI آگار آتیه سلامت محیط کشت سه خانه مک کانکی-XLD-EMB آتیه سلامت
محیط کشت سه خانه مک کانکی-XLD-EMB آتیه سلامت محیط کشت مولر هینتون آگار آتیه سلامت
محیط کشت مولر هینتون آگار آتیه سلامت محیط کشت دوخانه مک کانکی-EMB آتیه سلامت
محیط کشت دوخانه مک کانکی-EMB آتیه سلامت محیط کشت EMB آگار آتیه سلامت
محیط کشت EMB آگار آتیه سلامت محیط کشت نوترینت آگار آتیه سلامت
محیط کشت نوترینت آگار آتیه سلامت محلول ضد عفونی آکواریومی حجم 100 سی سی آتیه سلامت
محلول ضد عفونی آکواریومی حجم 100 سی سی آتیه سلامت محلول ضد قارچ آکواریومی حجم 100 سی سی آتیه سلامت
محلول ضد قارچ آکواریومی حجم 100 سی سی آتیه سلامت محلول ضد کلر آکواریومی حجم 100 سی سی آتیه سلامت
محلول ضد کلر آکواریومی حجم 100 سی سی آتیه سلامت محلول ضدعفونی کننده دست الکلی و غیرالکلی حجم یک لیتر آتیه سلامت
محلول ضدعفونی کننده دست الکلی و غیرالکلی حجم یک لیتر آتیه سلامت محلول فهلینگ A و B حجم یک لیتر آتیه سلامت
محلول فهلینگ A و B حجم یک لیتر آتیه سلامت معرف نین هیدرین 30 سی سی آتیه سلامت
معرف نین هیدرین 30 سی سی آتیه سلامت معرف کلروفریک 10% حجم 30 سی سی آتیه سلامت
معرف کلروفریک 10% حجم 30 سی سی آتیه سلامت محلول بافر TBE (10X) PCR حجم 100 سی سی آتیه سلامت
محلول بافر TBE (10X) PCR حجم 100 سی سی آتیه سلامت محلول بافر 7 و 3.5 حجم 100 سی سی آتیه سلامت
محلول بافر 7 و 3.5 حجم 100 سی سی آتیه سلامت محلول بافر 4،7،9 یک لیتری آتیه سلامت
محلول بافر 4،7،9 یک لیتری آتیه سلامت معرف اسیدکلریدریک 1 نرمال آتیه سلامت
معرف اسیدکلریدریک 1 نرمال آتیه سلامت معرف هیدروکسید سدیم 1 نرمال آتیه سلامت
معرف هیدروکسید سدیم 1 نرمال آتیه سلامت ست لوله شیشهای محیطهای کشت IMViC آتیه سلامت
ست لوله شیشهای محیطهای کشت IMViC آتیه سلامت سرم فیزیولوژی 50 سی سی استریل آتیه سلامت
سرم فیزیولوژی 50 سی سی استریل آتیه سلامت محیط کشت کلیگلر آیرون آگار KIA-لولهای آتیه سلامت
محیط کشت کلیگلر آیرون آگار KIA-لولهای آتیه سلامت محیط TSB حاوی گلیسیرین جهت نگهداری سوشهای استاندارد-لولهای آتیه سلامت
محیط TSB حاوی گلیسیرین جهت نگهداری سوشهای استاندارد-لولهای آتیه سلامت محیط کشت تایو گلیکولات براث-لولهای آتیه سلامت
محیط کشت تایو گلیکولات براث-لولهای آتیه سلامت محیط کشت سابورو دکستروز آگار SC-لولهای آتیه سلامت
محیط کشت سابورو دکستروز آگار SC-لولهای آتیه سلامت محیط کشت دوخانه مک کانکی-XLD آتیه سلامت
محیط کشت دوخانه مک کانکی-XLD آتیه سلامت محیط کشت دوخانه بلاد-مک کانکی آگار آتیه سلامت
محیط کشت دوخانه بلاد-مک کانکی آگار آتیه سلامت محیط کشت دوخانه مک کانکی آگار آتیه سلامت
محیط کشت دوخانه مک کانکی آگار آتیه سلامت محیط کشت سه خانه بلاد-مک کانکی-EMB آتیه سلامت
محیط کشت سه خانه بلاد-مک کانکی-EMB آتیه سلامت محیط کشت آماده مصرف عمومی مک کانکی آگار آتیه سلامت
محیط کشت آماده مصرف عمومی مک کانکی آگار آتیه سلامت محیط کشت دوخانه بلاد آگار آتیه سلامت
محیط کشت دوخانه بلاد آگار آتیه سلامت محیط کشت سه خانه بلاد آگار 8 سانتی آتیه سلامت
محیط کشت سه خانه بلاد آگار 8 سانتی آتیه سلامت محیط کشت آماده مصرف عمومی بلاد آگار آتیه سلامت
محیط کشت آماده مصرف عمومی بلاد آگار آتیه سلامت محیط کشت آماده مصرف افتراقی سلنیت F- لولهای آتیه سلامت
محیط کشت آماده مصرف افتراقی سلنیت F- لولهای آتیه سلامت محیط کشت آماده مصرف افتراقی آرژنین دهیدرولاز- لولهای آتیه سلامت
محیط کشت آماده مصرف افتراقی آرژنین دهیدرولاز- لولهای آتیه سلامت محیط کشت آماده مصرف افتراقی لایزین دکربوکسیلاز- لولهای آتیه سلامت
محیط کشت آماده مصرف افتراقی لایزین دکربوکسیلاز- لولهای آتیه سلامت محیط کشت آماده مصرف افتراقی اورنیتین دکربوکسیلاز- لولهای آتیه سلامت
محیط کشت آماده مصرف افتراقی اورنیتین دکربوکسیلاز- لولهای آتیه سلامت محیط کشت آماده مصرف افتراقی TSB- لولهای آتیه سلامت
محیط کشت آماده مصرف افتراقی TSB- لولهای آتیه سلامت محیط کشت آماده مصرف افتراقی OF لولهای آتیه سلامت
محیط کشت آماده مصرف افتراقی OF لولهای آتیه سلامت محیط کشت آماده مصرف افتراقی BHI براث- لولهای آتیه سلامت
محیط کشت آماده مصرف افتراقی BHI براث- لولهای آتیه سلامت محیط کشت آماده مصرف کروم آگار سودوموناس آئروژینوزا پلیت 6 سانتی آتیه سلامت
محیط کشت آماده مصرف کروم آگار سودوموناس آئروژینوزا پلیت 6 سانتی آتیه سلامت محیط کشت آماده مصرف کروم آگار استاف اورئوس پلیت 6 سانتی آتیه سلامت
محیط کشت آماده مصرف کروم آگار استاف اورئوس پلیت 6 سانتی آتیه سلامت محیط کشت آماده مصرف کروم آگار Orientation پلیت 6 سانتی آتیه سلامت
محیط کشت آماده مصرف کروم آگار Orientation پلیت 6 سانتی آتیه سلامت محیط کشت آماده مصرف کروم آگار کاندیدا پلیت 6 سانتی آتیه سلامت
محیط کشت آماده مصرف کروم آگار کاندیدا پلیت 6 سانتی آتیه سلامت محیط کشت آماده مصرف کروم آگار اشرشیاکلیO157 پلیت 6 سانتی آتیه سلامت
محیط کشت آماده مصرف کروم آگار اشرشیاکلیO157 پلیت 6 سانتی آتیه سلامت محیط کشت آماده مصرف کروم آگار اشرشیاکلی پلیت 6 سانتی آتیه سلامت
محیط کشت آماده مصرف کروم آگار اشرشیاکلی پلیت 6 سانتی آتیه سلامت محیط کشت آماده مصرف کروم آگار سالمونلا پلیت 6 سانتی آتیه سلامت
محیط کشت آماده مصرف کروم آگار سالمونلا پلیت 6 سانتی آتیه سلامت محیط کشت آماده مصرف افتراقی پپتون واتر- لولهای آتیه سلامت
محیط کشت آماده مصرف افتراقی پپتون واتر- لولهای آتیه سلامت محیط کشت آماده مصرف افتراقی بایل اسکولین آگار- لولهای آتیه سلامت
محیط کشت آماده مصرف افتراقی بایل اسکولین آگار- لولهای آتیه سلامت محیط کشت آماده مصرف افتراقی لایزین آیرون آگار- لولهای آتیه سلامت
محیط کشت آماده مصرف افتراقی لایزین آیرون آگار- لولهای آتیه سلامت محیط کشت آماده مصرف افتراقی فنیل آلانین آگار- لولهای آتیه سلامت
محیط کشت آماده مصرف افتراقی فنیل آلانین آگار- لولهای آتیه سلامت محیط کشت آماده مصرف افتراقی اوره آگار- لولهای آتیه سلامت
محیط کشت آماده مصرف افتراقی اوره آگار- لولهای آتیه سلامت محیط کشت آماده مصرف افتراقی سیمون سیترات- لولهای آتیه سلامت
محیط کشت آماده مصرف افتراقی سیمون سیترات- لولهای آتیه سلامت محیط کشت آماده مصرف افتراقی SIM- لولهای آتیه سلامت
محیط کشت آماده مصرف افتراقی SIM- لولهای آتیه سلامت محیط کشت آماده مصرف افتراقی MRVP- لولهای آتیه سلامت
محیط کشت آماده مصرف افتراقی MRVP- لولهای آتیه سلامت محیط کشت آماده مصرف افتراقی TSI- لولهای آتیه سلامت
محیط کشت آماده مصرف افتراقی TSI- لولهای آتیه سلامت محیط کشت برد پارکر آگار 8 سانتی آتیه سلامت
محیط کشت برد پارکر آگار 8 سانتی آتیه سلامت محیط کشت ستریمید آتیه سلامت
محیط کشت ستریمید آتیه سلامت محیط کشت TCBS آتیه سلامت
محیط کشت TCBS آتیه سلامت محیط کشت سابرو دکستروز آگار با کلرامفنیکل و سیکلوهگزامید 6 سانتی آتیه سلامت
محیط کشت سابرو دکستروز آگار با کلرامفنیکل و سیکلوهگزامید 6 سانتی آتیه سلامت محیط کشت سابرو دکستروز آگار با کلرامفنیکل 6 سانتی آتیه سلامت
محیط کشت سابرو دکستروز آگار با کلرامفنیکل 6 سانتی آتیه سلامت محیط کشت مولر هینتون آگار خوندار 10 سانتی آتیه سلامت
محیط کشت مولر هینتون آگار خوندار 10 سانتی آتیه سلامت محیط کشت سه خانه SS-مک کانکی-XLD آتیه سلامت
محیط کشت سه خانه SS-مک کانکی-XLD آتیه سلامت محیط کشت دوخانه SS-مک کانکی 8 سانتی آتیه سلامت
محیط کشت دوخانه SS-مک کانکی 8 سانتی آتیه سلامت محیط کشت SS آگار آتیه سلامت
محیط کشت SS آگار آتیه سلامت محیط کشت سه خانه مانیتول-بلاد-DNase آتیه سلامت
محیط کشت سه خانه مانیتول-بلاد-DNase آتیه سلامت محیط کشت DNase آتیه سلامت
محیط کشت DNase آتیه سلامت محیط کشت دوخانه بلاد-مانیتول سالت آگار آتیه سلامت
محیط کشت دوخانه بلاد-مانیتول سالت آگار آتیه سلامت محیط کشت مانیتول سالت آگار آتیه سلامت
محیط کشت مانیتول سالت آگار آتیه سلامت محیط کشت XLD آتیه سلامت
محیط کشت XLD آتیه سلامت محیط کشت شکلات آگار آتیه سلامت
محیط کشت شکلات آگار آتیه سلامت رنگ اتیدیوم بروماید آتیه سلامت
رنگ اتیدیوم بروماید آتیه سلامت کیت تشخیصی آزمایشگاهی آتیه سلامت
کیت تشخیصی آزمایشگاهی آتیه سلامت امولسیون زرده تخم مرغ آتیه سلامت
امولسیون زرده تخم مرغ آتیه سلامت محلول معرف آتیه سلامت
محلول معرف آتیه سلامت اوکالیپتول مایان گستر
اوکالیپتول مایان گستر دلتامترین مایان گستر
دلتامترین مایان گستر آبامکتین مایان گستر
آبامکتین مایان گستر روبناکوکسیب مایان گستر
روبناکوکسیب مایان گستر معرف کارل فیشر مایان گستر
معرف کارل فیشر مایان گستر استونیتریل مایان گستر
استونیتریل مایان گستر هیستیدین مایان گستر
هیستیدین مایان گستر محیط کشت مایان گستر
محیط کشت مایان گستر متانول مایان گستر
متانول مایان گستر هیدروکسید سدیم مایان گستر
هیدروکسید سدیم مایان گستر ویژگی های اصلی
| عکس اصلی محصول نیست | عکس اصلی محصول نیست | عکس اصلی محصول نیست |
مشخصات تأمین کننده
برند/فروشنده | آتیه سلامت | آتیه سلامت | آتیه سلامت |
مشخصات کالا
محل تولید و ارسال | کرج | کرج | کرج |
نوع مصرف | تجهیزات آزمایشگاهی | تجهیزات آزمایشگاهی | تجهیزات آزمایشگاهی |
شرایط خرید
نیاز به مشاوره خرید | |||
قابلیت مرجوعی | ندارد | ندارد | ندارد |





